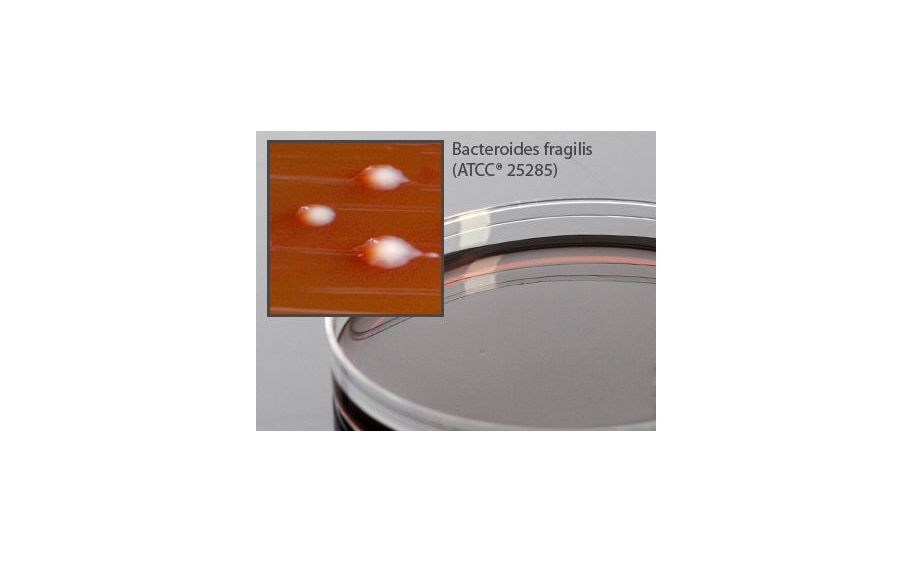
main product photo

Need Help?
800-229-7252

LKV AGAR REDUCIBLE F/ANAEROBES 15X100 MM
1
/
PK
Lead Time
12 Day(s)
SKU
VWR75846-312-PK
MFRPN
A60
LKV AGAR REDUCIBLE F/ANAEROBES 15X100 MM
LKV Agar 15x100mm plate LKV (Brucella Agar with Laked Sheep Blood, Kanamycin, Vancomycin, Hemin and Vitamin K) Agar, reducible, For the selective isolation of gram negative anaerobic bacteria, especially Bacteroides species, Size: 15x100mm plate
| Manufacturer | Hardy Diagnostics |
|---|---|
| MFRPN | A60 |
| Lead Time | 12 Day(s) |
| UNSPSC Code | 12000000 |
| Product Type | Plasticware |
| Discipline | Microbiology |
Write Your Own Review